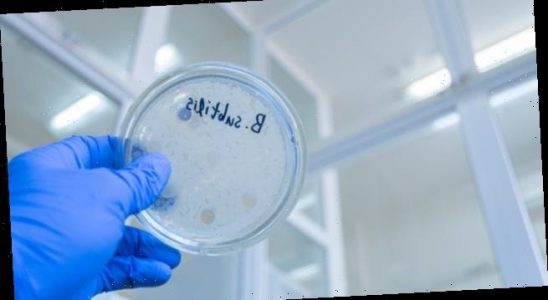

Zink und Immunsystem: Sind Sie fit für die Beratung?
Bei der Abwehr von Atemwegsinfekten ist ein starkes Immunsystem gefragt. Wie Zink dazu beitragen kann, ist jetzt ein relevantes Thema in der Apotheke. Sind Sie fit für die Beratung? Zink…
Tierversuche: USA erlauben Arzneimittelzulassung mit Alternativen
In den Vereinigten Staaten hat Präsident Joe Biden kürzlich ein Gesetz unterzeichnet, dass es gestattet, neue Arzneimittel künftig auch ohne Tierversuche zuzulassen. Tierschutzorganisationen jubeln, während Wissenschaftler skeptisch sind, ob es…
Paracetamol plus Ibuprofen: Nutzen und Risiken der neuen Fixkombination
„Nehmen Sie Ibuprofen und Paracetamol mit ausreichendem Abstand ein“ – dieser Beratungshinweis gehört im Handverkauf der Vergangenheit an. Die bisher verschreibungspflichtige Kombination beider Analgetika kann künftig rezeptfrei verkauft werden. Synofen®…
Bacillus subtilis: Wissenswertes über die Mikrobe des Jahres
Mit Bacillus subtilis wurde 2023 ein äußerst vielseitiges Bakterium von der „Vereinigung für Allgemeine und Angewandte Mikrobiologie“ zur Mikrobe des Jahres gekürt. Eingesetzt wird Bacillus subtilis unter anderem in der Gesundheitsförderung,…
Wie das EuGH-Urteil von 2016 mich in die Berufspolitik trieb
Die apothekerliche Berufspolitik ist komplex. Die DAZ will von jungen Kammer- und Verbandsvorständen wissen, weshalb es sich trotzdem lohnt, sich einzubringen, welche Ziele sie sich gesetzt haben und welche Einstiegshürden…
Mein liebes Tagebuch
Jetzt wird’s ernst: Die Bürokratiemonster sind für den Abschuss freigegeben. Die ABDA jagt sie, sogar mit einer eigenen Arbeitsgruppe, und die Politik will ihnen den Garaus machen, sie packt den…
Deuterierung vereinfachen: Wie Arzneimittel länger im Körper bleiben
Eine junge Forscherin am Leibniz-Institut für Katalyse in Rostock hat eine günstigere Methode entwickelt, in organischen Molekülen Wasserstoffatome durch das schwerere Isotop Deuterium auszutauschen. Arzneimittel erhalten so etwa eine höhere…
E-Rezept knackt 1-Million-Marke
996.941 eingelöste E-Rezepte zeigt das TI-Dashboard der Gematik aktuell an – Stand gestern. Die E-Rezept-Enthusiasten jubeln: Sie erwarten für heute die Einlösung der einmillionsten elektronischen Verordnung. Nächste Woche wollen sie…
„Blinder Fleck in der Entwicklung“
Die Teamsoftware Apocollect von Simon und Gerrit Nattler will die internen Kommunikationsprozesse von Apotheken vereinfachen und effektiver machen. Dafür hat Simon seine vier Apotheken an den Bruder verkauft und konzentriert…
Berlin zieht Ende der Maskenpflicht auf Anfang Februar vor
Die deutschen Amtsärzte fordern angesichts der derzeitigen Corona-Welle in China eine europaweite Testpflicht für alle Einreisenden aus dem Land. In fünf weiteren Bundesländern kommt das Ende der Maskenpflicht. In der…